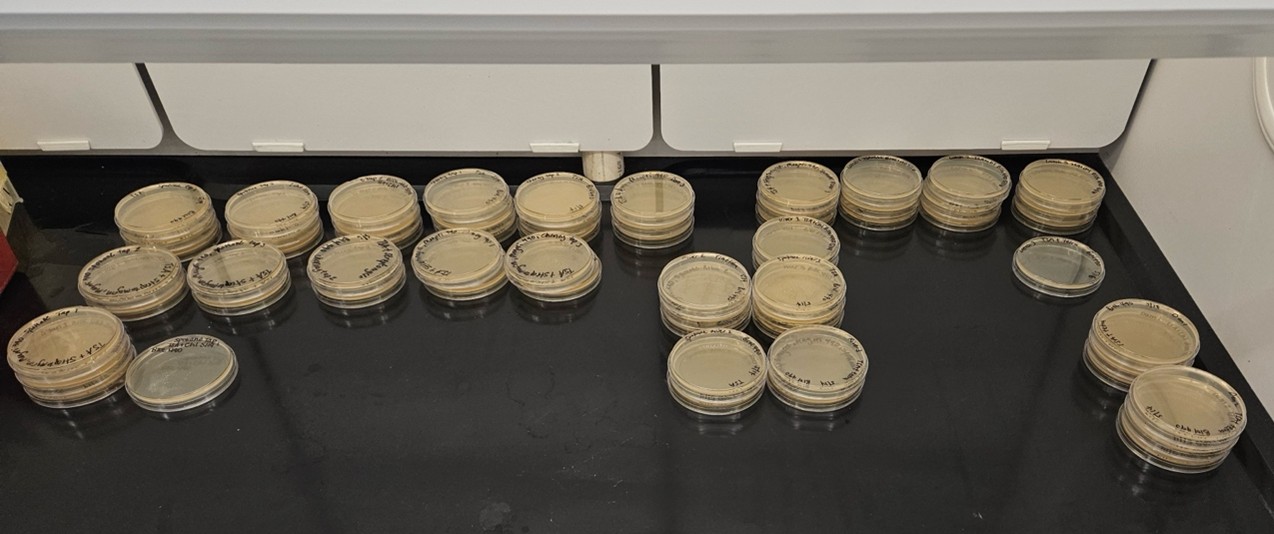

Empowering the next generation of biologists with One Health skills and principles into an uncertain future
Published in Ecology & Evolution, Microbiology, and Zoology & Veterinary Science
We live in highly uncertain times. People lived in uncertainty for millenia, but with at least two major wars raging at the moment, and a generational restructuring at the federal level in the United States, with global economic and political ramifications, things just feel different. As a Professor of Biology at a regional public institution in the US, I feel relatively powerless to protect my students, both those on campus, as well as those graduating into the workforce, from the consequences of the chaos surrounding them. The one thing I can do is to continue showing up and focus on serving them in the best way I can, by providing them with skills and knowledge that might be useful to them in the future. That is exactly what I was trying to do in my classes this Spring quarter at Eastern Washington University, including in my Disease Ecology Senior Capstone class.
This class, that I teach every Spring, focuses on how hosts, vectors and pathogens interact with each other and their biotic and abiotic environment, and provides the principles and skills relevant to the One Health framework. In the classroom, we discuss the various roles that pathogens and parasites can play in ecosystems and how characteristics of ecosystems, such as diversity and human impacts can determine the dynamics of parasites and pathogens that in turn impact humans, livestock and wildlife. In the lab, after introducing students to methods such as dragging for ticks, students develop research projects, in partnership with local agencies, on locally relevant host-parasite or pathogen system, which exemplify the global issues we discuss in class.
This Spring quarter, as in previous years, I was honored to be able to teach an excellent, smart, enthusiastic group of students. We had great discussions in class, and they developed excellent projects, which you can read about below. They also gave oral presentations at our EWU Creative Works and Research Symposium, presented posters on their research at the end of the quarter, and wrote individual scientific manuscripts detailing their findings as their final assignments. In addition to these, they served their community by investigating ticks at a specific location in our area, in response to a request by our local health department, for potential Lyme disease exposure. Fortunately, only Dermacentor ticks were found, which do not transmit Borrelia burgdorferi, the bacteria responsible for causing Lyme disease.
Many of the students graduated this Saturday, moving on to pursuing careers such as veterinarians, science teachers, psychiatrists, wildlife management professionals, and many others. Given that parasites and pathogens, and their ecosystem and human impacts are likely to increase in the future, the knowledge and skills they developed in my class might serve them well one day. While I do worry about their future in these crazy times, the work ethic and professionalism that they demonstrated in my class fills me with hope that they will be able to handle any obstacles that life throws at them. I'm looking forward to seeing what they will accomplish in the future!
Nematode (C. multipapillatum) presence in brook stickleback (Culaea inconstans) at Turnbull National Wildlife Refuge
Authors: Sydni Goulding, Dylan Smith, Mason Thompson
Our group's project in Dr. Magori’s Disease Ecology Course, investigated how a nematode (Contraceacum multipapillatum) is infecting Brook Stickleback (Culaea inconstans) at Turnbull National Wildlife Refuge. Our work continued off of a previous graduate student's work, Sarah Flores, who had spent her time seeking the prevalence of nematode infections. We continued her previous investigation in Middle Pine Lake. To investigate, we collected and dissected stickleback from Middle Pine Lake, while also sampling zooplankton and sediments for parasite DNA. Using visual inspection, we confirmed that a small number of fish were infected with C. multipapillatum. Interestingly, infected fish were significantly larger—suggesting that older or more dominant individuals may be at greater risk. However, our environmental DNA analysis did not detect nematode DNA in water samples, possibly due to the use of non-specific primers. Still, our findings highlight the value of pairing traditional parasitology with modern molecular tools to track parasite dynamics in wild ecosystems.
Assessment of Antibiotic-Resistant Bacteria in Wastewater Effluent and Surface Waters in the Spokane Region
Authors: Hailey Hendry, Sayla Merritt, and Oluwapelumi Sonoiki
Antibiotic resistance is one of today’s largest growing health threats. This phenomenon develops as bacteria evolve mechanisms that allow them to overcome the effects of antibiotics inhibiting their growth. The development of antibiotic-resistant bacteria (ARB) has potentially detrimental effects on both public and environmental health. The spread of ARB within environmental sources can occur through human activity, agriculture, or industrial pathways which includes wastewater treatment plants (WWTPs). WWTPs have the potential to harbor and spread ARB throughout water systems. Our study conducted at Eastern Washington University evaluated the presence or absence of bacteria and ARB, in local industrial and natural water systems and the role these water systems may play in the spread of ARB.
Water samples were collected from two WWTPs, three natural water sources, and two tap water sources all within the Spokane region. By plating samples onto control TSA plates, we were able to determine if bacteria was present in our collected samples; through the preparation of TSA plates spiked with solutions of ampicillin, chloramphenicol, streptomycin, and tetracycline, we were able to determine if any ARB were present in our collected samples as well.
It was found that natural water sources in Spokane exhibited the most bacterial growth, with high levels of antibiotic resistance. Both WWTP effluent and tap water samples had little bacteria with a small amount of ARB, allowing us to determine that current treatments are working but not perfectly. While WWTPs are relatively successful in the removal of bacterial contamination from influent, the Spokane River and Latah Creek still act as ‘hotspots’ for ARB. Further sampling and additional monitoring should be established to help mitigate the environmental impact ARB may have in the greater Spokane region.
Investigating Ecological Factors of Small Mammal and Tick Abundance
Authors: Angelea Borodin, Makenna Collins, Tobiah Eddy, Alivia Gies, Antonete Partido
Ticks are important vectors of numerous diseases, and their populations are closely tied to the availability of suitable hosts. Small mammals, particularly rodents, play a key role in supporting tick life cycles and maintaining tick-borne pathogens in the environment. We hypothesized that areas with higher small mammal abundance will exhibit higher levels of ticks, as greater host availability may support larger tick populations. Additionally, ticks should be positively correlated with % live shrub cover and small mammal abundance should be positively correlated with % forb cover as they utilize these annuals for digestible food during the spring.
We set live traps at multiple habitat types overnight and checked them the following morning for study subjects. Captured small mammals' weight, height, and sex was measured and identified and they were then carefully examined for ticks. All ticks found were collected, counted, and preserved. Trapping in a variety of locations allowed us to compare different environmental conditions and vegetation to then assess how habitat variation influences small mammal and tick populations.
We found no correlation between tick and small mammal abundance or between ticks and % live shrub cover. We did, however, find a positive correlation between small mammals and % forb cover. By analyzing these patterns, we aim to better understand host-parasite dynamics and the factors that contribute to the risk of tick-borne disease. This project provides valuable understanding of tick/host dynamics in Eastern Washington, while contributing important insights into the field of disease ecology.
Follow the Topic
-
BugBitten
A blog for the parasitology and vector biology community.
Please sign in or register for FREE
If you are a registered user on Research Communities by Springer Nature, please sign in